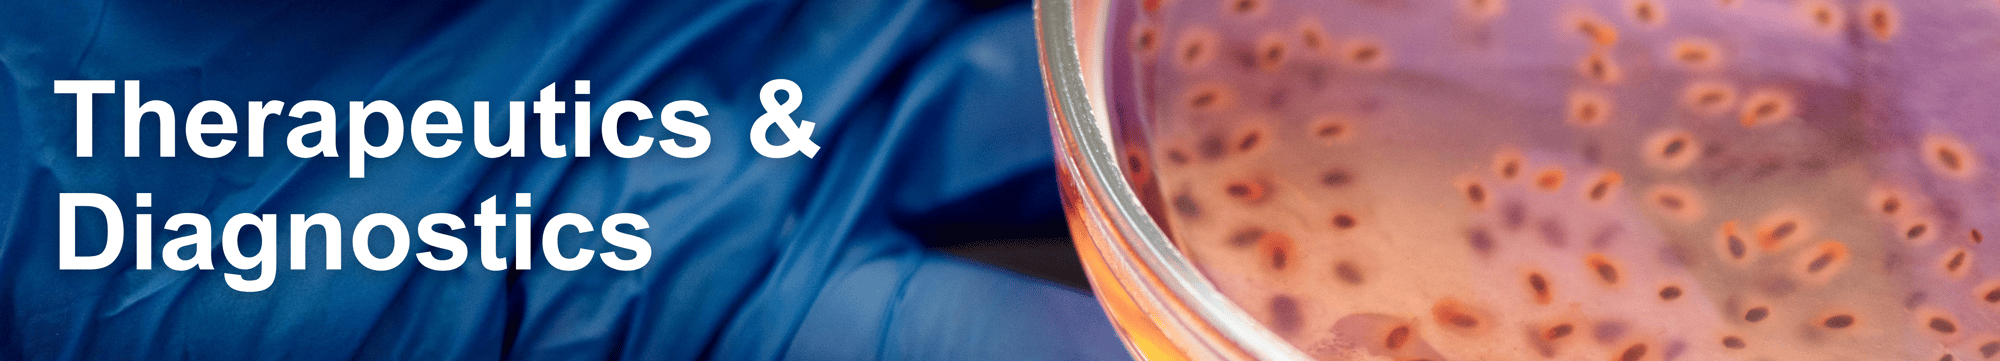
Therapeutics & Diagnostics Therapeutics & Diagnostics

We welcome potential partners to explore our portfolio of innovative therapeutics and diagnostics technologies available for licensing.
Cleveland Clinic Innovations' technologies address real clinical needs across specialties - from brain-targeted allosteric activators of the α1A-Adrenergic Receptors for the treatment of cognition disorders to PhotoSorb - a polyhydroxy fullerene topical sunscreen. These innovations enable more precise procedures, reduced pain, improved visualization, and more, all backed by Cleveland Clinic's clinical expertise.
All technologies are available for licensing. Our Business Development and Licensing experts provide comprehensive support from evaluation through commercialization.
Please click on the individual technology titles below to learn more about the therapeutics and diagnostics technologies that are available for licensing.
Brain-Targeted Allosteric Activators of the α1A-Adrenergic Receptor
- Small molecule therapy for the treatment of cognition disorders.
- First in class, small molecule, Allosteric Activator, α1A-Adrenergic Receptor.
- Enabling studies completed with positive safety and efficacy data.
Inhibitors of Hexose-6-Phosphate Dehydrogenase a Novel Therapeutic for Metastatic Castration Resistant Prostate Cancer
- Leverages fundamental metabolic mechanism that drives AR antagonist resistance.
• Novel inhibitors may be utilized as stand-alone or part of synergistic therapy.
• In-vivo proof-of-concept established by experienced drug discovery and development team.

Antibody Against Ovarian Cancer for Use in Liquid Biopsy Tests
Monoclonal antibody for ovarian cancer cell capture using magnetic separation, enhancing sensitivity of liquid biopsy diagnostics.
Nanoparticles for Drug Delivery to Treat Bone Metastasis
Biodegradable, neutral-charge nanoparticles to deliver anti-cancer drugs directly to bone metastasis sites.
Erythritol & Cardiovascular Disease Risk
Isotope dilution method to distinguish and quantify erythritol.
Gene Expression Profile for Immunotherapy Efficacy in Melanoma Patients
Diagnostic test to predict immunotherapy efficacy.
Trymethyllysine: A TMAO Precursor as a Predictor of CVD Risk
Plasma metabolite biomarker that predicts cardiovascular risk.
Diagnostic Method for Multiplex Detection and Quantification of Cell-Free HPV-16 DNA
Single-Tube hrHPV Genotype Specific Real-Time Polymerase Chain Reaction (qPCR) Assay for Detection of Cell-Free hrHPV DNA in human plasma and body fluids.
Human Factor VII Deletion Constructs for Treating Brain Cancer
Small recombinant protein therapeutic that inhibits brain tumor growth and therapy resistance, as well as negating cancer-associated adverse hypercoagulation state.
Rapid Self-Contained Breathalyzer Test System
A rapid point of care diagnostic
device for detection of pathogens
in exhaled breath.
Inhibitors of Hexose-6-PhosphateDehydrogenase as a Novel Therapeutic for Metastatic, Castration Resistant Prostate Cancer (CRPC)
Hexose-6-Phosphate Dehydrogenase (H6PD)
Inhibitors.
TET Inhibitor Treatment for Myelodysplastic Syndromes
Potent small molecule inhibitor of TET dioxygenase.
Small Molecule Modulators of ER Stress Response for Multiple Myeloma
Small molecule that inhibits protein disulfide isomerase (PDI) blocking a key survival mechanism for multiple myeloma cells.
Anti-C6 Antibody Therapy for Complement Mediated Diseases
Therapeutic antibody targeting complement component 6 (C6).
Precision Manufacturing of Functionally Enriched CAR T Cells
Novel method for functional enrichment of T cell pools.
HLTH
Cleveland Clinic Innovations is heading to HLTH 2025 from October 19–22! Our team will join healthcare leaders in Las Vegas to explore this year’s key themes: AI and emerging tech, cardiometabolic health, women’s health, health equity, and more.
We’ll be connecting with innovators, investors, and industry partners to discuss how our portfolio of digital health and healthcare technologies is shaping the future of care through strategic licensing and partnerships. We’re also looking forward to hearing from Cleveland Clinic leaders shaping the future of care, including Tom Mihaljevic, MD, CEO & President, and Rohit Chandra, PhD, Chief Digital Officer.
If you're attending HLTH, we’d love to connect. Let’s turn breakthrough ideas into real-world solutions.
Connect with our team:
• Gerald J. Wilmink, PhD, MBA - Director, Business Development
• Sonja OMalley, MBA, PMP - General Manager, Business Development
• Linda Li, MSc, CFA - Partner, Ventures
• Todd Schwarzinger, MBA - Partner, Ventures
Expansion Across the Globe
Global Research, Education + Innovations
“Cleveland Clinic supports caregivers by fostering an environment of creativity and openness to explore how things can be done differently for the benefit for all patients. This culture of innovation is a core value that permeates throughout our entire ecosystem.”
Joseph Iannotti, MD, PhD
Chief Research and Academic Officer at Cleveland Clinic Florida
